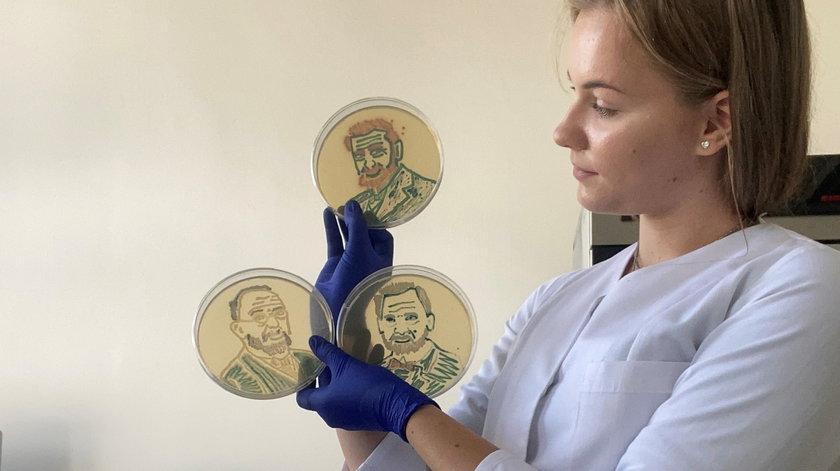

Studentka z Poznania maluje bakteriami. Teraz ma szansę wygrać prestiżowy konkurs
23-11-2022 • undefined min czytania


fot. Uniwersytet Przyrodniczy w Poznaniu/ materiały prasowe
Farby porzuciła na rzecz bakterii, płótnem stał się dla niej chemiczny agar, a pędzlem - eza będąca pętlą bakteriologiczną. Nie, to nie eksperyment z lekcji biologii, ale... sztuka mikrobiologiczna zwana Bioart. Martyna Pietrzak, poznańska studentka weterynarii, tworzy portrety sławnych osób ze świata nauki i jako jedyna Polka zakwalifikowała się do międzynarodowego konkursu „Agar Art”.
Polecane

„Piękne, oszałamiające, niekomfortowe”. Wystawa Magdaleny Abakanowicz w Tate Modern

Jakub Gierszał w zwiastunie międzynarodowego thrillera szpiegowskiego Jana Holoubka

„To nie ma sensu”. Lily-Rose Depp nie chce być postrzegana jako „dziecko nepotyzmu”

Raf Simons zamyka swoją markę po blisko 30 latach. To koniec pewnej ery

„Sparaliżowało mnie”. Natalia Przybysz była molestowana przez członków rodziny

Bruce Willis w tragicznym stanie. Hollywood się martwi
Polecane

„Piękne, oszałamiające, niekomfortowe”. Wystawa Magdaleny Abakanowicz w Tate Modern

Jakub Gierszał w zwiastunie międzynarodowego thrillera szpiegowskiego Jana Holoubka

„To nie ma sensu”. Lily-Rose Depp nie chce być postrzegana jako „dziecko nepotyzmu”

Raf Simons zamyka swoją markę po blisko 30 latach. To koniec pewnej ery

„Sparaliżowało mnie”. Natalia Przybysz była molestowana przez członków rodziny